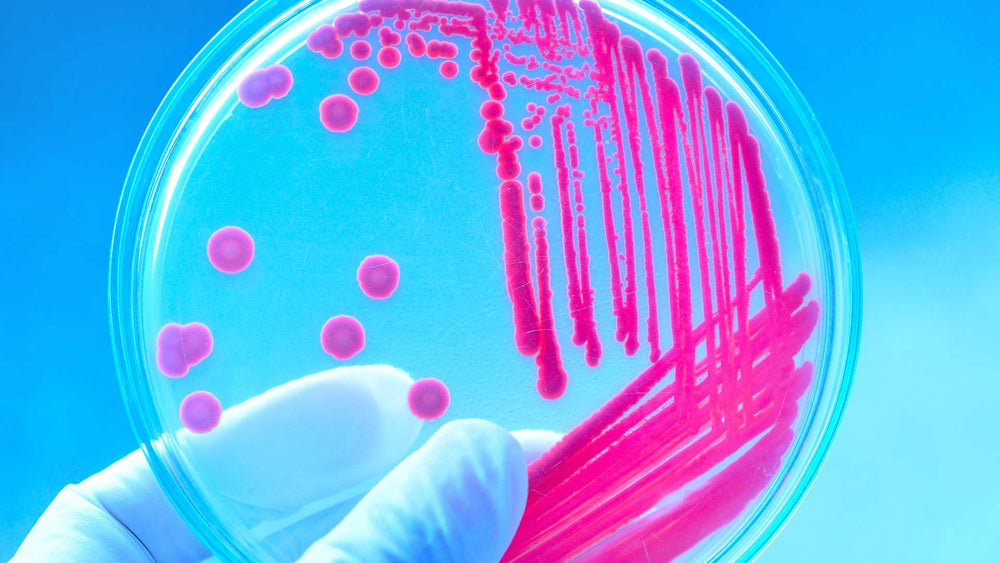

What’s the Difference Between Resident and Transient Strains?
Just like a city THRIVES with a mix of locals and tourists, so does your gut! Here’s a look at both resident and transient bacteria, and why a healthy microbiome needs BOTH:
Resident bacteria strains, aka permanent gut dwellers, live on the walls of your intestinal tract. There they form a coating that protects against pathogenic (“unfriendly”) bacteria.
Think of resident bacteria like you would think of the locals who have lived in a city for a long time. They fiercely love their city and will defend it (and its sports teams) to anyone who challenges them.
Transient probiotic strains, aka temporary visitors, follow the digestive process and are eventually evacuated from the body. Transient probiotics are helpful in fighting certain types of bacteria, and are important to the immune system.
Think of transient bacteria like you would think of tourists. Tourists come for a short period only, and while they’re visiting, they give the local economy a boost.
At any given time, both locals and tourists bring their love to a city and make it thrive! Resident and transient bacteria have the same effect in the gut, too!
Many other probiotics on the market are largely based on Lactobacillus acidophilus and Lactobacillus rhamnosus, two resident strains with excellent colonization capabilities but limited in their ability to fully contribute without other transient strains to assist them!
advanced gut health probiotic is a multi-strain probiotic that contains both resident and transient species of bacteria:
advanced gut health probiotic contains 15 strains of bacteria that are not only a mix of resident and transient strains, but were selected to mimic healthy human gut flora. Our multi-strain formula doesn’t simply add 15 bacterium to the digestive tract for a short period – it allows bacteria who are dependent on them to grow and flourish, having a greater exponential effect. Multi-strain formulas are PROVEN to be more effective than single-strain formulas: In 75% of the cases where multi-strain formulas were tested against single strain formulas, multi-strains were more effective.
This is just one of the ways that we have carefully created advanced gut health probiotic. Our unique formula that contains a wider variety of fit and strong bacteria strains, coupled with a targeted delivery system has been shown to deliver up to 10X the bacteria to your gut – so you love how you feel.
Resident bacteria strains
Resident bacteria strains, aka permanent gut dwellers, live on the walls of your intestinal tract. There they form a coating that protects against pathogenic (“unfriendly”) bacteria.
Think of resident bacteria like you would think of the locals who have lived in a city for a long time. They fiercely love their city and will defend it (and its sports teams) to anyone who challenges them.
Transient bacteria strains
Transient probiotic strains, aka temporary visitors, follow the digestive process and are eventually evacuated from the body. Transient probiotics are helpful in fighting certain types of bacteria, and are important to the immune system.
Think of transient bacteria like you would think of tourists. Tourists come for a short period only, and while they’re visiting, they give the local economy a boost.
At any given time, both locals and tourists bring their love to a city and make it thrive! Resident and transient bacteria have the same effect in the gut, too!
Many other probiotics on the market are largely based on Lactobacillus acidophilus and Lactobacillus rhamnosus, two resident strains with excellent colonization capabilities but limited in their ability to fully contribute without other transient strains to assist them!
advanced gut health probiotic is a multi-strain probiotic that contains both resident and transient species of bacteria:
- Resident strains in advanced gut health probiotic: Lactobacillus helveticus, Lactobacillus acidophilus, Bifidobacteria bifidum, Bifidobacteria breve, Bifidobacteria longum, Bifidobacteria infantis, Lactobacillus animalis, and Lactobacillus rhamnosus.
- Transient strains in advanced gut health probiotic: Lactobacillus casei, Lactobacillus plantarum, Lactobacillus paracasei, Lactobacillus bulgaricus, and Streptococcus thermophilus.
advanced gut health probiotic contains 15 strains of bacteria that are not only a mix of resident and transient strains, but were selected to mimic healthy human gut flora. Our multi-strain formula doesn’t simply add 15 bacterium to the digestive tract for a short period – it allows bacteria who are dependent on them to grow and flourish, having a greater exponential effect. Multi-strain formulas are PROVEN to be more effective than single-strain formulas: In 75% of the cases where multi-strain formulas were tested against single strain formulas, multi-strains were more effective.
This is just one of the ways that we have carefully created advanced gut health probiotic. Our unique formula that contains a wider variety of fit and strong bacteria strains, coupled with a targeted delivery system has been shown to deliver up to 10X the bacteria to your gut – so you love how you feel.